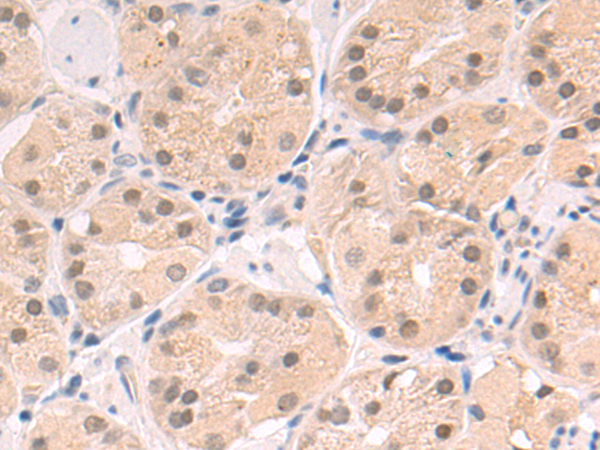

别名:UP2; UPASE2; UDRPASE2应用:WB,IHC
反应种属:Human, Mouse
规格:50μl/100μl
| Description |
|---|
| Catalyzes the reversible phosphorylytic cleavage of uridine and deoxyuridine to uracil and ribose- or deoxyribose-1-phosphate. The produced molecules are then utilized as carbon and energy sources or in the rescue of pyrimidine bases for nucleotide synthesis. Shows substrate specificity and accept uridine, deoxyuridine, and thymidine as well as the two pyrimidine nucleoside analogs 5-fluorouridine and 5-fluoro-2(‘)-deoxyuridine as substrates. |
| Specification | |
|---|---|
| Aliases | UP2; UPASE2; UDRPASE2 |
| Swissprot | O95045 |
| WB Predicted band size | 36 kDa |
| Host/Isotype | Rabbit IgG |
| Storage | Store at 4°C short term. Aliquot and store at -20°C long term. Avoid freeze/thaw cycles. |
| Species Reactivity | Human, Mouse |
| Immunogen | Synthetic peptide of human UPP2 |
| Formulation | pH7.4 PBS, 0.05% NaN3, 40% Glycerol |
| Application | |
|---|---|
| WB | 1/500-1/2000 |
| IHC | 1/50-1/200 |
| ELISA | 1/5000-1/10000 |
 |
Gel: 8%SDS-PAGE, Lysate: 40 μg, Lane 1-3: Mouse kidney tissue, Mouse brain tissue, Mouse heart tissue lysates, Primary antibody: P05497(UPP2 Antibody) at dilution 1/700, Secondary antibody: Goat anti rabbit IgG at 1/5000 dilution, Exposure time: 3 minutes |
 |
The image is immunohistochemistry of paraffin-embedded Human tonsil tissue using P05497(UPP2 Antibody) at dilution 1/55. (Original magnification: ×200) |
|
The image is immunohistochemistry of paraffin-embedded Human gastric cancer tissue using P05497(UPP2 Antibody) at dilution 1/55. (Original magnification: ×200) |
本公司的所有产品仅用于科学研究或者工业应用等非医疗目的,不可用于人类或动物的临床诊断或治疗,非药用,非食用。
暂无评论
本公司的所有产品仅用于科学研究或者工业应用等非医疗目的,不可用于人类或动物的临床诊断或治疗,非药用,非食用。
 中文
中文 








发表回复